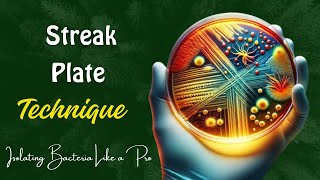

🌟 Welcome to Our Biological Science Channel! 🌟
Passionate research enthusiasts have created this channel to simplify Biological Science concepts and provide practical knowledge in an engaging and accessible way. Our mission is to break down complex ideas and help you excel in your studies.
On this channel, we explore a variety of Bio-Science experiments with detailed, step-by-step explanations. Whether you’re a Bachelor’s or Master’s student, a research scholar, or an industrial trainee, our content is designed to inspire and support you on your scientific journey.
🔬 What You’ll Discover:
In-depth explanations of microbiology and biotechnology experiments
Clear and straightforward scientific concepts
Effective techniques for retaining knowledge
Join us in exploring the wonders of science and make learning an exciting adventure!
📚 Don’t forget to like, comment, and subscribe to stay updated with our latest educational content and become part of our science enthusiast community!
Shared 4 days ago
16 views
Shared 2 weeks ago
22 views
Shared 1 month ago
40 views
Shared 1 month ago
29 views
Shared 1 month ago
27 views
Shared 2 months ago
105 views
Shared 3 months ago
77 views
Shared 3 months ago
76 views
Shared 4 months ago
120 views
Shared 4 months ago
83 views
Shared 4 months ago
241 views
Shared 4 months ago
54 views
Shared 5 months ago
56 views
Shared 5 months ago
188 views
Shared 5 months ago
482 views
Shared 5 months ago
26 views
Shared 6 months ago
117 views
Shared 6 months ago
47 views
Shared 6 months ago
103 views
Shared 7 months ago
299 views
Shared 7 months ago
15 views
Shared 7 months ago
2.4K views
Shared 7 months ago
33 views
Shared 8 months ago
3.6K views
Shared 8 months ago
143 views
Shared 8 months ago
661 views
Shared 8 months ago
545 views
Shared 9 months ago
1.6K views
Shared 9 months ago
1K views
Shared 9 months ago
30 views
Shared 10 months ago
367 views
Shared 10 months ago
572 views
Shared 11 months ago
80 views
Shared 11 months ago
190 views
Shared 11 months ago
162 views
Shared 11 months ago
1.6K views
Shared 11 months ago
39 views
Shared 11 months ago
42 views
Shared 1 year ago
231 views
Shared 1 year ago
62 views
Shared 1 year ago
99 views
Shared 1 year ago
17 views
Shared 1 year ago
387 views
Shared 1 year ago
246 views
Shared 1 year ago
387 views
Shared 1 year ago
200 views
Shared 1 year ago
167 views
Shared 1 year ago
188 views
Shared 1 year ago
206 views
Shared 1 year ago
254 views
Shared 1 year ago
49 views
Shared 1 year ago
450 views
Shared 1 year ago
206 views
Shared 1 year ago
1.1K views
Shared 1 year ago
246 views